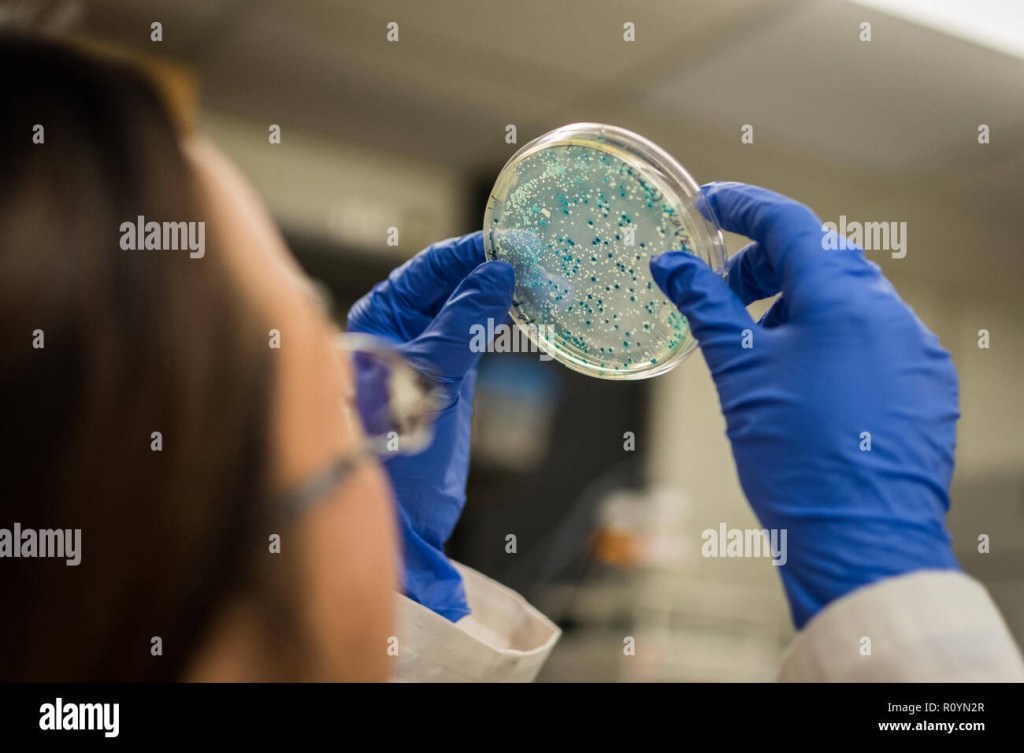

“This study is a stepping stone towards understanding how medications affect our gut microbiome. In the future, we might be able to use this knowledge to tailor prescriptions to reduce drug side effects.”
-Peter Bork, Group Leader and the Director, EMBL Heidelberg.
The research compared two groups; one consisted of a those bacterium that were cultured in isolation while the other was part of a large microbial community and were tested on the basis of drug-microbiome reactions. The team investigated how 30 different drugs interacted against 32 different bacterial species. These 32 species represented those microbes found in the human gut, thanks to the data available from 5 continents. What they had discovered was unexpected. The bacteria species that were affected by a drug in isolation, were thriving in the complex microbial community. Certain drug-resistant bacteria were found to behave in such a way wherein the sensitive bacterium to those particular drugs were protected. This ‘cross-protection’ behaviour gives the opportunity to the sensitive bacterium to grow in an environment which would have killed them if they were isolated. The findings of this study, were published in the journal Cell. “We were not expecting so much resilience.” said Sarela Garcia-Santamarina, a group leader at the Instituto de Technologia Química e Biológica (ITQB). Universidade Nova de Lisboa, Portugal and the first co-author of the study.
The researchers wanted to dig deeper to uncover the mechanisms of this cross protection. These bacteria help each other, breaking down the products; processes known as bio-accumulation and bio-transformation. The strength of this bacterial community is limited to high drug concentrations. The ‘cross-sensitisation’ strategy replaces the ‘cross-protection’ strategy. Here, the resistant bacteria start to turn sensitive to the drugs when in a community. This is an opposite effect compared to the lower drug concentrations. Negative interactions also emerge, and this sensitises more bacterial community members.
The Typas Group contributed with the experimental microbiome and the microbiology approaches, the Bork Group was occupied with the bio-informatics, the Zimmermann Group did the metabolomics studies and the Savitski Group performed the proteomics experiments. They are also studying how the interspecies of microbes interact through nutrient influence, so that, better models can be created to help further our understanding of the interactions between bacteria, drugs and the human host.
Image and Information Credit: https://www.alamy.com/microbiome-and-microbiology-research-in-laboratory-image224344031.html,